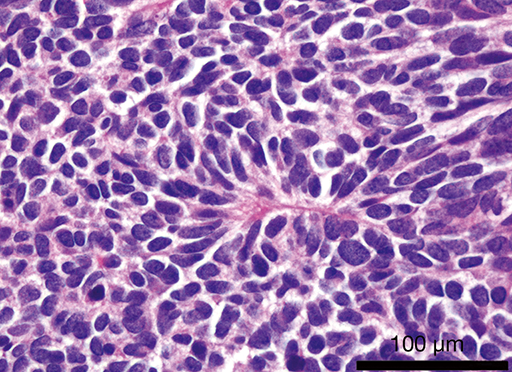

Quais padrões de calcificação são preocupantes em um nódulo pulmonar?

SALPICADO
EXCÊNTRICO
Características de MALIGNIDADE de um nódulo pulmonar?
Qual tipo de CA broncogênio?
ADENOCARCINOMA
(40% dos casos)

Que tipo de CA broncogênico tem como manifestação paraneoplásica a osteoartropatia hipertrófica pulmonar?

ADENOCARCINOMA
Quais são os CA broncogênicos PERIFÉRICOS?

ADENOCARCINOMA
GRANDES CÉLULAS

Quais são os CA broncogênicos CENTRAIS

CARCINOMA EPIDERMOIDE
OAT CELL

CA Broncogênicos que CAVITAM?

EPIDERMOIDE
GRANDES CÉLULAS
Que CA broncogênico faz SÍNDROME DE PANCOAST?


EPIDERMOIDE
(céls escamosas)
Que CA broncogênico cursa com HIPERCALCEMIA?


EPIDERMOIDE
(EPTHdermoide)
(céls escamosas)
Que CA Broncogênico pode fazer Síndrome da Veia Cava Superior?

OAT CELL

CA Broncogênico que pode cursar com
OAT CELL
Quando não realizamos cirurgia em um TUMOR PULMONAR?
NÃO OPERAR (apenas QT +- RT)
Obs:
T4 = tumor > 7cm ou invasão de outra estrutura
N2 = linfonodos mediastinais ipsilaterais
N3 = linfonodos mediastinais contralaterais
M1 = metástase